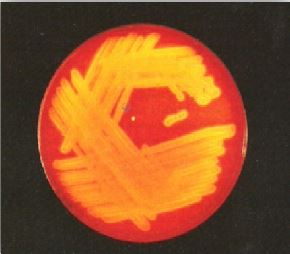
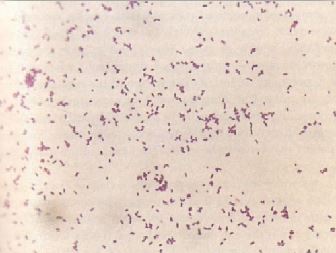

الحالات المرضية البكتيرية : الحالة الثالثة عشر
 المؤلف:
عبد الرزاق سليمان التومي ، محمد محمد الامام ، عبد الباسط رمضان
المؤلف:
عبد الرزاق سليمان التومي ، محمد محمد الامام ، عبد الباسط رمضان
 المصدر:
اساسيات التشخيص البكتريولوجي المعملي والسريري
المصدر:
اساسيات التشخيص البكتريولوجي المعملي والسريري
 الجزء والصفحة:
الجزء والصفحة:
 31-8-2016
31-8-2016
 1931
1931
الحالات المرضية البكتيرية : الحالة الثالثة عشر
مريض يتناول علاج مثبط للجهاز المناعي immunosuppressive therapy بعد إجراءه لعملية زرع الكلية ، بدأ بالشعور بارتفاع في درجة الحرارة وصداع شديد مع نوبات صرع وعدم وجود الوذمة الحليمية البصرية papilloedema تم إرسال عينة من سائل النخاع الشوكي (CSF) للمختبر لفحصخا مجهرياً وزراعتها ، مخبرياً تبين أن عدد كرياتا لدم البيضاء كان 1000/ مم3 (79% منهم كانوا متعددي الأشكال polymorphs) ، معدل البروتين كانت 1.0 جرام/لتر ، ومستوى سكر الجلوكوز كان 3.0 ميلليمول /لتر .
لم تظهر الشريحة التي تم صبغها بصبغة جرام وجدو أي مستعمرات بكتيرية تم عزل الكائن الممرض من سائل النخاع الشوكي وأعيد زراعته من جديد subculture فكان كما في الشكل رقم1 ، ونتيجة الصبغ بصبغة جرام كانت كما في الشكل رقم 2 ، وتم عزل نفس هذا الكائن الدقيق من عينة الدم.
الشكل رقم 1 : المزرعة البكتيرية
الشكل رقم 2 : الفحص المجهري
الأسئلة :
1- ما تشخيصك المتوقع لهذه الحالة المرضية ؟
2- ما مصدر الإصابة بهذا النوع من الجنس البكتيري؟
3- كيف ستتم معالجة هذا المريض؟
4- من هم الأشخاص الأكثر عرصة للإصابة بهذا الكائن الدقيق ؟
وكيف يمكن منع حدوث هذه الإصابة ؟
الإجابة :
1- غالباً ما يصاب الأشخاص الذي يعانون من قصور في وظيفة الجهاز المناعي بمرض التهاب السحايا نتيجة الإصابة بالنوع البكتيري Listeria monocytogenes إلا أن عددها يكون قليلاً جداً في سائل النخاع الشوكي في حوالي 60% من الحالات تكون نتيجة صبغ العينة سالبة بحيث لا تظهر وجد أي مستعمرات بكتيرية والاستجابة المناعية سريعة ويسمى التهاب السحايا الصديدي pyogenic meningitis ، ويرتفع عندها معدل البروتين واستجابة كريات الدم البيضاء وخاصة كريات الدم البيضاء متعددة الأشكال polymorphs كما في حالة هذا المريض، ويكون معدل سكر الجلوكوز طبيعي في حوالي 60% من الحالات إلا إذا كانت هناك إصابة بكتيرية اخرى، غالباً ما تكون إصابات الجهاز العصبي المركزي الناتجة من الإصابة بالجنس البكتيري Listeria Spp مصحوبة بظهور علامات التهاب السحايا والدماغ، ا تكون الـ abcess ، وقد يصاب المريض بنوبات ترنح ، كما ان نتيجة عينة الدم تكون موجبة في 60% من الحالات.
يكون النوع البكتيري L. monocytogenes على هيئة عصيات موجبة لصبغة جرام كما في الشكل رقم 1.13 وينمو في درجات حرارة مختلفة ولكنه ينمو ببطء في درجة حرارة 4 درجات مئوية ، وهناك 7 انواع من هذا الجنس البكتيري واهمها النوع البكتيري L. monocytogenes وهو الوحيد الجنس البكتيري واهمها النوع البكتيري L. monocytogenes وهو الوحيد الذي يسبب أمراض للإنسان وقد تعرف المستعمرات النامية عن طريق الخطأ بانها النوع البكتيري dephteroids ويتم تجاهلها على اعتبار أنها من تلوث عارض، ولهذا النوع البكتيري خاصية مميزة في الحركة يمكن ملاحظتها مجهرياً.
2- يتواجد هذا الجنس البكتيري في بيئات مختلفة فقد نجده في البيئات المائية والتربة وكذلك الأراضي الزراعية كما أنه يتواجد بشكل كبير في العديد من الحيوانات على سبيل المثال قد نجده في الأغنام ، الأبقار ، الطيور وكذلك الأسماك. كما أنه تم الكشف على أعداد كبيرة من هذا الجنس البكتيري في عينات من الجبن واللحم ويعتبر تناول الأغذية الملوثة وخاصة الحليب ومشتقاته المصدر الاساسي لانتقال المرض للإنسان.
3- يعتبر النوع البكتيري L. monocytogenes حساساً للعديد من المضادات الحيوية ويعتبر العلاج المكون من المضاد الحيوي ampicillin والمضاد الحيوي gentamicin هو العلاج الأمثل وقد يتم استعمال المضاد الحيوي cotrimoxazole كعلاج بديل للأشخاص الذين لديهم حساسية مفرطة لمركبات B- Lactam .
4- في الغالب ما تتم الإصابة بهذا النوع البكتيري في الثلث الثالث من الحمل ويكون على هيئة انفلونزا ، وأن عبور هذه البكتيريا عبر امشيمة قد يؤدي للإجهاض او إصابة المولود ، ولتفادي ذلك يتم الاهتمام بغذاء الأم الحامل كالتوقف عن تناول الحليب الغير معالج وكذلك الجبن غير المطبوخ.
 الاكثر قراءة في البكتيريا
الاكثر قراءة في البكتيريا
 اخر الاخبار
اخر الاخبار
اخبار العتبة العباسية المقدسة


